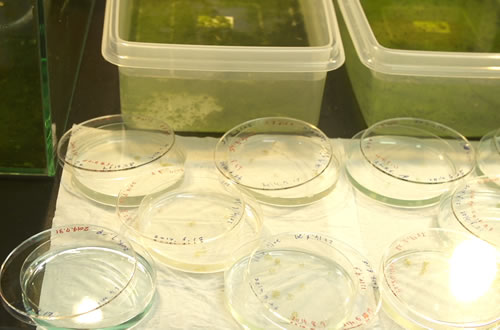

HWIP履修後の変化・成長 ~ Before/After ~
ヒューマンウェアの履修生や教員の方々は、またヒューマンウェアを通して出会う方々は、相当に多種多様かつ優秀な (すごい経歴の) 人ばかりだったので、大抵の人に出会っても驚かなくなった気がします。成長できた点はたくさんありますが、例えば日々のディスカッションで異分野に対する抵抗が減り、また融合研究の経験から共同研究のハードルもすごく下がりました。専門研究をやりつつヒューマンウェア関連の作業もすることで、マルチ作業能力も飛躍的に向上しました。(情報科学研究科・修了/1期生)

「異分野融合」
情報・生体・認知の包括的な知識を身につけるための授業や融合研究を通して、異なる分野のメンバーと共創するための知識や調整力を磨きます。

自身の興味に真っ直ぐで様々なことに臆せず挑戦していく履修生に囲まれることで、自身も物事に対して前向きに挑戦できる人間に成長しています。(生命機能研究科/ 5期生)
普通の大学院生と比較すると、生物・情報・工学の幅広い知識に触れる機会が得られ、研究を進める上でいろんな角度からヒントが得られるようになった。また、学内外の活動に取り組む機会や支援を多く得られたことで、積極的に物事に取り組む姿勢が身についたと思う。(生命機能研究科/ 5期生)

「斉同熟議」
徹底的な議論により、背景知識の異なる相手に自分の考えを伝える力を磨きます。


相手の研究分野やバックグラウンドを常に意識して議論やコミュニケーションする姿勢を身につけることができた。(基礎工学研究科/ 4期生)
自らの専門分野に偏らず、ほかの科学分野や社会問題など幅広いことに興味をもてるようになった。(生命機能研究科/ 5期生)



学生自主企画「ビジネスモデル創成ワークショップ」
履修開始当初から目標に掲げていたことだが、多面的に物事を見る力がついたと思う。専門分野の研究について議論する際も、もちろん意識せねばならなかった部分だが、異分野研究者や文化の違う異国の方々と議論する際には、より多面的な考え方が必要であるので、多面的に考えることが自然と習慣付き、日常の中でも、物事を一面的に捉えず深く考えるようになった。 (情報科学研究科/ 4期生)
自分の研究の意義を伝えることを意識するようになった。既に得られた事実について検討する研究室での議論とは異なり、外部の人からは、その研究を活かして何が出来るかこれから先の未来について見られていることが分かった。研究室とは異なる視点で研究を見つめられるようになって、専門研究を進める上でも意義があったと思う。(生命機能研究科/ 2期生)



学生自主企画「耳コピハッカソン合宿」
異分野の方々との交流を通じ、視野が広がったと感じます。もし履修していなければ、自身の専門研究分野以外のことを知る機会がほとんどなかっただろうと思います。(情報科学研究科/ 2期生)
HWIPは非常に自由度が高く、異才の同志たちと融合研究をしたり、国内外の訪問や交流の機会を得たり、理論と実践でリーダーシップを学べたり、多様で有意義な活動に能動的に従事することができました。そうした経験を通じて、“自ら進んで選択しチャレンジするという精神”と、“多角的・本質的な物事の捉え方”を養うことができたと考えています。ずっと井の中の蛙だった私が、HWIPを通じて大海を知り、大海原へ泳いでいくことができるようになりました。(情報科学研究科/ 2期生)



学生自主企画「出張・西岡塾」
自身の専門外の領域の研究者らとの斎同熟議を介して、様々に視座・視点を変えながら、研究 (事業) 領域の理解・課題抽出・解決策の立案を俯瞰的に考えられるようになった。(情報科学研究科・修了/1期生/)
異分野間の融合研究などを通してマネジメントに関する経験が積めたこと。また、通常接点のない同世代の優秀な学生との会話や議論を通じて受けた刺激によって、思考や将来観に対する視野が広がったと感じる。(情報科学研究科・修了/1期生 )
